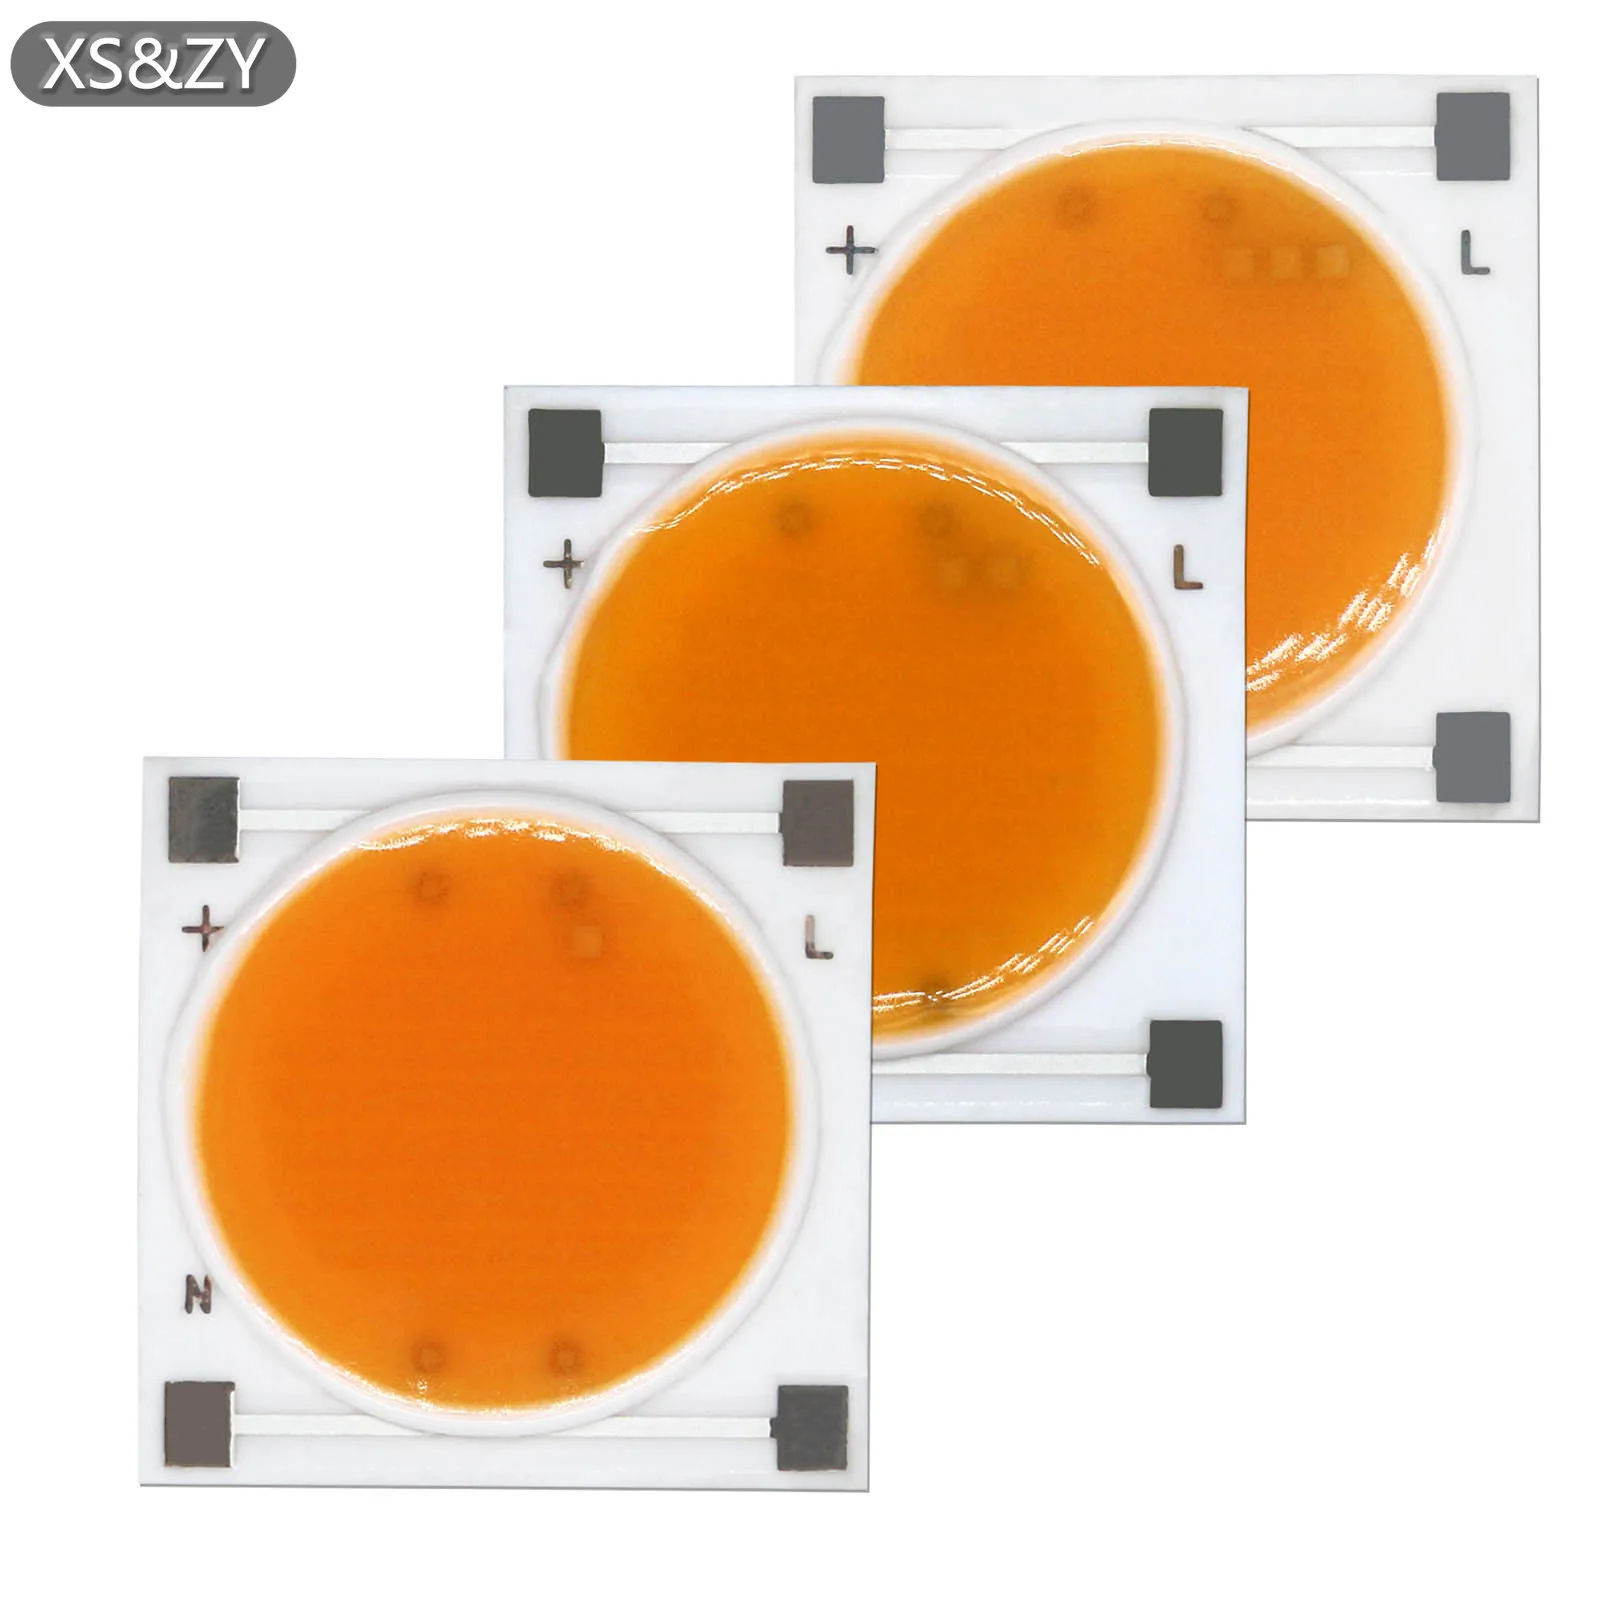

Welcome to Buydo. Check our Special Deals - up to 80% off.

















Dostarczyć do
 Algeria
Algeria Andorra
Andorra Armenia
Armenia Australia
Australia Austria
Austria Azerbaijan
Azerbaijan Bahrain
Bahrain Belgium
Belgium Brazil
Brazil Bulgaria
Bulgaria Canada
Canada Chile
Chile Colombia
Colombia Croatia (Hrvatska)
Croatia (Hrvatska) Cyprus
Cyprus Czech Republic
Czech Republic Denmark
Denmark Dominican Republic
Dominican Republic Ecuador
Ecuador El Salvador
El Salvador Estonia
Estonia Finland
Finland France
France Georgia
Georgia Germany
Germany Greece
Greece Hungary
Hungary Iceland
Iceland India
India Ireland
Ireland Israel
Israel Italy
Italy Japan
Japan Jordan
Jordan Kazakhstan
Kazakhstan Kuwait
Kuwait Latvia
Latvia Lithuania
Lithuania Luxembourg
Luxembourg Malaysia
Malaysia Malta
Malta Mauritius
Mauritius Mexico
Mexico Moldova
Moldova Morocco
Morocco Netherlands
Netherlands New Zealand
New Zealand Norway
Norway Oman
Oman Panama
Panama Peru
Peru Philippines
Philippines Poland
Poland Portugal
Portugal Puerto Rico
Puerto Rico Qatar
Qatar Republic of Korea
Republic of Korea Romania
Romania Saudi Arabia
Saudi Arabia Serbia
Serbia Slovakia
Slovakia Slovenia
Slovenia South Africa
South Africa Spain
Spain Sweden
Sweden Switzerland
Switzerland Trinidad and Tobago
Trinidad and Tobago Türkiye
Türkiye United Arab Emirates
United Arab Emirates United Kingdom
United Kingdom United States
United States Uruguay
Uruguay Uzbekistan
Uzbekistan Virgin Islands (U.S.)
Virgin Islands (U.S.)
- GBP
- EUR
- USD
- CAD
- AUD
- USDT
- Deutsch
- English
- Français
- Latviešu
- Polish
- Türkçe
- हिंदी
- 日本語
- 中文
Zaloguj się / Zarejestruj się
RachunekZaloguj się / Zarejestruj się
RachunekJęzyk:
- Deutsch
- English
- Français
- Latviešu
- Polish
- Türkçe
- हिंदी
- 日本語
- 中文
Dostarczyć do
 Algeria
Algeria Andorra
Andorra Armenia
Armenia Australia
Australia Austria
Austria Azerbaijan
Azerbaijan Bahrain
Bahrain Belgium
Belgium Brazil
Brazil Bulgaria
Bulgaria Canada
Canada Chile
Chile Colombia
Colombia Croatia (Hrvatska)
Croatia (Hrvatska) Cyprus
Cyprus Czech Republic
Czech Republic Denmark
Denmark Dominican Republic
Dominican Republic Ecuador
Ecuador El Salvador
El Salvador Estonia
Estonia Finland
Finland France
France Georgia
Georgia Germany
Germany Greece
Greece Hungary
Hungary Iceland
Iceland India
India Ireland
Ireland Israel
Israel Italy
Italy Japan
Japan Jordan
Jordan Kazakhstan
Kazakhstan Kuwait
Kuwait Latvia
Latvia Lithuania
Lithuania Luxembourg
Luxembourg Malaysia
Malaysia Malta
Malta Mauritius
Mauritius Mexico
Mexico Moldova
Moldova Morocco
Morocco Netherlands
Netherlands New Zealand
New Zealand Norway
Norway Oman
Oman Panama
Panama Peru
Peru Philippines
Philippines Poland
Poland Portugal
Portugal Puerto Rico
Puerto Rico Qatar
Qatar Republic of Korea
Republic of Korea Romania
Romania Saudi Arabia
Saudi Arabia Serbia
Serbia Slovakia
Slovakia Slovenia
Slovenia South Africa
South Africa Spain
Spain Sweden
Sweden Switzerland
Switzerland Trinidad and Tobago
Trinidad and Tobago Türkiye
Türkiye United Arab Emirates
United Arab Emirates United Kingdom
United Kingdom United States
United States Uruguay
Uruguay Uzbekistan
Uzbekistan Virgin Islands (U.S.)
Virgin Islands (U.S.)
Waluta
- GBP
- EUR
- USD
- CAD
- AUD
- USDT
Witamy spowrotem!
Nowy klient?
Dołącz za darmo













Opisy
Name: Plant Growth LightVoltage: AC220VPower: 10W/20W/30WLumen: 800lm/1600lm/2400lmBand: 380-840nmSize: 19*19mmLight-emitting surface: 17mmThickness: 1: CeramicThermal conductivity: 8/m·KAnti-surge: 4KVScene application: plant light lighting, plant advancement bulbs





Recenzja
0 people rated this product
No reviews
Provided by:Vertical
10W 20W 30W Ceramics Base LED COB Chip AC220V Smart IC Diode For Flower Pot Family Greenhouse Plant LED Growth lighting bulb DIY
0.0
-33%$ 22.92$ 36.30
VAT included
Rozmiar: 10W 800lm 10PCS

Ilość
Tylko 291 pozostało w magazynie
Provided by Vertical. Ships from BUYDO
Free shipping & returns
Dostawa: 5-9 business days
Courier company:
 QWQER Express,
QWQER Express, USPS,
USPS, DHL
DHL
Shopping security
- Safe payment options
- Secure privacy
- Secure logistics
- Purchase protection
